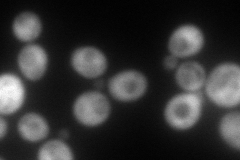
YPL088W
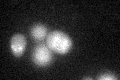
YPL088W

View description
Putative aryl alcohol dehydrogenase; transcription is activated by paralogous transcription factors Yrm1p and Yrr1p along with genes involved in multidrug resistance
Localization:
Intensity:
Fold change:
Significance:
-
C’ GFP library in SD

below threshold16.57 -
N' NOP1pr-GFP in SD

cytosol159.179 -
N' TEF2pr-mCherry in SD
cytosol175.643 -
N' NATIVEpr-GFP in SD

punctate21.1766 -
N' TEF2pr-VC and Cyto-VN in SD

#N/A0 -
C’ GFP library in SD+DTT
cytosol17.941.08No -
C’ GFP library in SD+H2O2

cytosol16.280.98No -
C’ GFP library in Starvation Media

cytosol18.281.1No -
C’ GFP library on the background of Pup2-DaMP

below threshold -
C’ GFP library on the background of CCT mutant

below threshold17.04941.02809No
